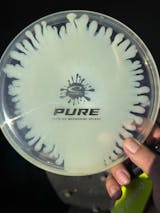
User picture

Discraft Limited Edition Victory Edition 2025 LWS Open Champion Paul McBeth Confetti Elite Z Buzzz SS Midrange Golf Disc
SPEED
5
GLIDE
4
TURN
-2
FADE
1
Regular price
€21,95 EUR
Unit price
/
Unavailable
Brand: Discraft
Model: Buzzz SS
Disc Type: Midrange
Plastic: Elite Z Confetti
Paul McBeth's win at the 2025 LWS Open at Idlewild marked his first DGPT victory since 2023—a return to dominance that only Paul could deliver. The Victory Edition Buzzz SS honors that performance with the trusted Buzzz feel, tuned for straight, controlled flights with a touch of finesse. A must-have for players and collectors alike.
Manufacturer's Flight Ratings:
Joe's Universal Flight Chart:
| Stability | Speed | Glide | Turn | Fade |
| 0.0 | 5 | 4 | -2 | 1 |
| RNG | HSS | LSS | PWR |
| 3 | -1 | +1.5 | 1 |
OVER 30 YEARS
As a Trusted Global Distributor
OVER 3,000,000
Discs Sold
OVER 300,000
Discs Available
OVER 30,000
Exact Discs
Discraft Limited Edition Victory Edition 2025 LWS Open Champion Paul McBeth Confetti Elite Z Buzzz SS Midrange Golf Disc

![Lightning Sure Grip #1 Driver [Retool] Fairway Driver Golf Disc](http://gottagogottathrow.com/cdn/shop/files/LTSG-RT-_1_Driver.jpg?v=1740762223&width=1000)
